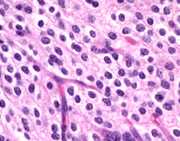

M2 NEUROPATHOLOGY LAB
QUIZ 10 (microscopicpathology)
Case A
Case B
Case C
Case D
Case E
Match your diagnoses with images 46-50.
46 47
47 48
48 49
49 50
50
Case A
A 7 year old boy was an unrestrained passenger inthe front seat when the car in which he was ridingwas hit by another car on the left side. The airbag deployed, hitting him in the left temple. Inthe ER, he was unconscious, responding only to painfulstimuli by extensor spasms. He had a scalp lacerationand fractures of the skull and left jaw. One weekafter the accident, he was still unconscious. Hispupils and eye movements were normal, corneal andgag reflexes were present, and he had no facial weakness.He had weakness, spasticity and brisk tendon reflexeson the right. Both plantar responses were extensor.He lay most of the time with eyes open and had coordinatedeye movements following sounds and moving objects.He appeared to sleep at times but could be roused.He died of pneumonia and sepsis 10 days after theaccident.
Case B
A 4 year old boy had headaches and frequent vomitingin the morning for 2 weeks. Examination by a pediatricianand gastroenterology referral revealed no abnormalities.The symptoms worsened. He became incoordinated andhis vision became blurred. Fundoscopic exam revealedpapilledema. MRI showed a cystic cerebellar mass.A posterior fossa craniotomy was done and a partlycystic lesion was removed.
Case C
A 39-year-old woman with Hodgkin’s disease developeda rapid succession of neurologic deficits. First, therewas left facial weakness, followed by ataxia and weaknessof the left hand. One month later, a left visual fieldcut appeared, then left hemiparesis. CSF was normal.MRI showed areas of demyelination without mass effect.Two months later, right hemiparesis and upward gazeparalysis appeared. Gradually she became comatose anddied four months after the onset of her illness.
Case D
A 14 year old boy had buzzing in the left earand tingling and pain in the left face for oneyear. Loss of hearing and vetigo gradually developed.Neurological examination revealed weakness andsensory loss on the left face. MRI revealed a2.5 cm extra-axial mass in the left cerebellopontineangle, extending into the left auditory meatus.His mother had a spinal cord tumor removed whenshe was 34 years old. The tumor was removed entirelythrough a posterior fossa craniotomy.
Case E
A 61 year old man had a history of focal seizuresinvolving the left arm for 4 years. Gradually,weakness and spasticity of the left arm and facedeveloped. Imaging studies reveiled an isodensepoorly defined, nonenhancing mass in the rightposterior frontal area, above the Sylvian fissure.The lesion involved cortex and white matter.Fine calcification was noted on the CT. A biopsywas done.
ALL LECTURE PODCASTS ARE EMBEDDED IN THEIR RESPECTIVENEUROPATHOLOGY PAGES AND CAN ALSO BE FOUND ON THEVIMEO CHANNEL"DIMITRIAGAMANOLIS NEUROPATHOLOGY"
[8]ページ先頭